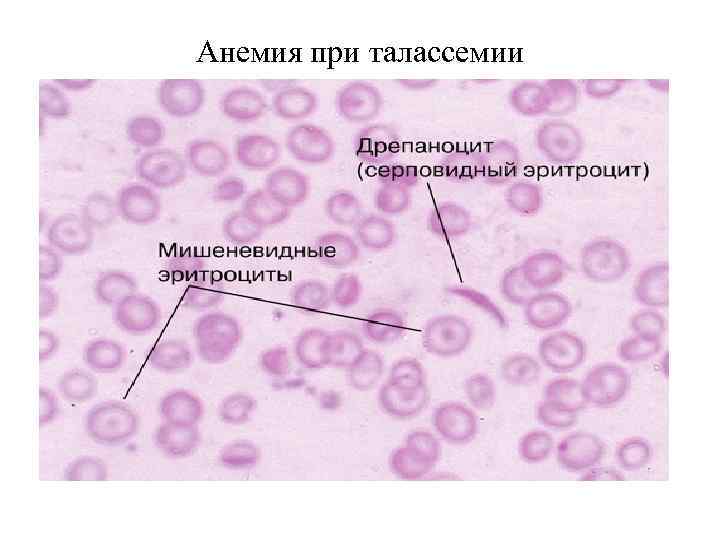
Анемия при талассемии
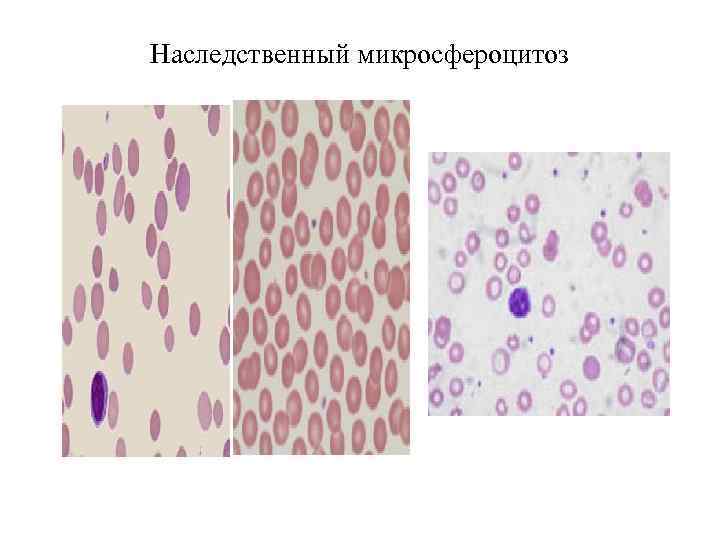
Наследственный микросфероцитоз

лекцйииГематология(15-16).ppt
- Количество слайдов: 169

Обзорная лекция по кредиту «Гематология» для студентов 4 курса по специальности «общая медицина» на 2015 -2016 учебный год Лектор доцент кафедры внутренних болезней № 1 Краснова С. А.

Кроветворение (гемопоэз) Кроветворение (гемопоэз) – процесс образования и развития форменных элементов крови в кроветворных органах. Эритроциты, зернистые лейкоциты, моноциты и тромбоциты образуются в костном мозге (эритропоэз, гранулопоэз, моноцитопоэз, тромбоцитопоэз), лимфоциты – в костном мозге, селезенке и тимусе (лимфоцитопоэз). Все клетки крови имеют одну родоначальную форму – стволовую кроветворную клетку. Кровь – внутренняя среда организма, жидкость, содержащая клеточные элементы, заключенная в кровеносной системе и пребывающая в постоянной циркуляции благодаря деятельности сердца и экстракардиальных факторов

Кроветворение (гемопоэз)

Обсуждаемые вопросы на лекции 1. Анемии (железодефицитная, в 12 -дефицитная, апластическая, гемолитические) 2. Гемобластозы (острые лейкозы, хронические лейкозы (хронический миелолейкоз, хронический лимфолейкоз, эритремия) 3. Геморрагические диатезы (аутоиммунная тромбоцитопеническая пурпура, геморрагический васкулит, гемофилия)

Форменные элементы крови (норма)

Что Вы видите на слайде?

Классификация анемий 4 уровень Анемия и анемический синдром – наиболее часто встречаемая патология системы крови. Анемии – клинико – лабораторный синдром, возникающий вследствие уменьшения в крови концентрации гемоглобина и эритроцитов в единице объема крови. По данным ВОЗ анемиями страдают около 2 млрд. людей в мире. Различают: • Железодефицитная анемия • В 12 -дефицитная анемия • Апластическая, гипопластическая анемия • Гемолитические анемии

Анемия

Классификация анемии (Л. И. Идельсон, 1975) I. Анемии вследствие кровопотерь: - острая постгеморрагическая анемия; - хроническая постгеморрагическая анемия, II. Анемии вследствие нарушенного кровообразования: - гипо -, апластическая анемия; - В 12 - дефицитная анемия; - геморрагические диатезы; - железодефицитная анемия. III. Анемии вследствие повышенного кроворазрушения: - аутоиммунная гемолитическая анемия; - болезнь Маркиафава - Микели (ПНГ); - болезнь Минковского - Шоффара

Разделение анемий по признаку цветности эритроцитов (П. А. Воробьев, 2001). Цветность эритроцитов (цветовой показатель – ЦП). - нормохромия эритроцитов ЦП = 0. 9 (гемолитические, апластическая, парциальная красноклеточная аплазия, анемии при хронических заболеваниях, но могут быть гипохромными). - гипохромия эритроцитов ЦП < 0. 85 (железодефицитные, сидероахрестические, анемии при хронических заболеваниях, но могут быть нормохромными). - гиперхромия эритроцитов ЦП>1. 1 (В 12 – дефицитная анемия, фоливодефицитная анемия)

Классификация по степени тяжести анемии (П. А. Воробьев, 2001). - анемия без клинических проявлений, гемоглобин снижается до 90 гл, - анемический синдром умеренной степени выраженности (характеризуется в основном слабостью, могут иметь место признаки сидеропении, полиневропатии, уровень гемоглобина выше 70 г/л и ниже 90 гл), - выраженный анемический синдром (появление сердцебиения на фоне вышеперечисленных симптомов, признаков сердечно – сосудистой недостаточности), уровень гемоглобина ниже 70 г/л), - анемическая прекома (на фоне вышеперечисленных симптомов присоединяются спутанность сознания, уровень эритроцитов и гемоглобина прогрессивно снижается), - анемическая кома (отсутствие сознания, иногда отмечается расстройство дыхания, уровень гемоглобина ниже 20 г/л, эритроцитов – ниже 1. 0 Х 10. 12/л)

Классификация Причины возникновения анемий: 1. Анемия вследствие недостаточного поступления в организм (железа, витамина В 12) – в основном характер питания 2. Анемия вследствие нарушенного всасывания (железа, витамина В 12) – в основном заболевания ЖКТ 3. Анемия вследствие повышенного расхода (железа, витамина В 12) – гельминты, беременность

жалобы-анемический синдром Отмечают общую слабость, возникает мышечная слабость, недомогание, снижение работоспособности. головокружения, шум в ушах, мелькание мушек перед глазами, одышка, сердцебиение и др. В большинстве случаев снижение уровня гемоглобина происходит постепенно (в отличие от острых кровопотерь), при этом различные органы адаптируются к анемии, в связи с чем жалобы больных не всегда соответствуют показателям содержания гемоглобина. Многие пациенты, особенно женщины, свыкаются со своим недомоганием, приписывая его переутомлению, психическим и физическим перегрузкам. Нередко больных впервые заставляют обращаться к врачу обморочные состояния. При снижении содержания гемоглобина у больных с ишемической болезнью сердца могут учащаться приступы стенокардии, увеличивается потребность в нитроглицерине, снижается толерантность к физической нагрузке

клиническая картина (анемический синдром)

Клиническая картина при анемии Кожные покровы и слизистые (бледность)

Метаболизм железа

Гемограмма при железодефицитной анемии В гемограмме имеется: 1. Микросфероцитоз 2. Гипохромия 3. Анизоцитоз 4. Пойкилоцитоз

Клиническая картина В клинической картине заболевания можно отметить наличие анемического синдрома, синдрома дефицита железа (синдром гипосидероза), гематологического. Бледность кожных покровов, которая часто имеет алебастровый или зеленоватый оттенок (название данного вида анемии - хлороз (зелень). Часто отмечается бледность слизистых и «синева» склер (симптом голубых с клер), легко возникающий румянцем щек, кожа становится сухой, дряблой, шелушится, легко образуются трещины. Затруднение глотания сухой и твердой пищи (сидеропеническая дисфагия-синдром Пламмера - Винсона), проявляющийся затруднением при глотании сухой и плотной пищи, чувством першения и ощущением наличия инородного тела в глотке. Некоторые больные связи с этими проявлениями принимают только жидкую пищу, что вынуждает врача подозревать опухолевое поражение пищевода. У больных снижаются вкусовые ощущения, появляются покалывание, жжение и чувство распирания в языке, особенно его кончике. У девочек, реже у взрослых женщин, возможны дизурические расстройства, иногда недержание мочи при кашле, смехе, что придает урологическую направленность обследованию подобных пациентов. У детей могут наблюдаться симптомы ночного энуреза. Могут наблюдаться извращение вкуса, сухость и пощипывание языка, нарушение глотания с ощущением инородного тела в горле (синдром Пламмера - Винсона), дисфагия

Клиническая картина при железодефицитной анемии В 25% случаев наблюдается глоссит и изменения полости рта. При осмотре обнаруживаются атрофические изменения слизистой оболочки языка, иногда трещины на кончике и по краям, трещины губ, в более тяжелых случаях – участки покраснения не правильной формы ( «географический язык» ) и афтозные изменения, атрофия сосочков языка, хейлит ( «заеды» в углах рта), изменения зубной эмали

клиническая картина при железодефицитной анемии Изменениями кожи, ногтей и волос. Кожа обычно бледная, иногда с легким зеленоватым оттенком (хлороз) и с легко возникающим румянцем щек, она становится сухой, дряблой, шелушится, легко образуются трещины. Специфичны изменения ногтей: они становятся тонкими, матовыми, уплощаются, легко расслаиваются и ломаются, появляется исчерченность. При выраженных изменениях ногти приобретают вогнутую, ложкообразную форму (койлонихия)

Гемограмма при железодефицитной анемии Признаки гипохромной микроцитарной анемии, снижение концентрации гемоглобина. Количество эритроцитов вначале может быть нормальным. При значительном дефиците железа оно также снижается, но в меньшей степени, чем уровень гемоглобина, низкий цветовой показатель (0, 7 -0, 5) и уменьшение средней концентрации гемоглобина в эритроцитах. Уменьшаются размеры эритроцитов (микроцитов) и их насыщенность гемоглобином (гипохромия). В мазках крови преобладают небольшие гипохромные эритроциты, аннулоциты (эритроциты с отсутствием гемоглобина в центре, в виде колец), эритроциты неодинакового размера и формы (анизоцитоз, пойкилоцитоз). При тяжелых анемиях могут появляться отдельные эритробласты. Количество ретикулоцитов не изменено. Только при анемии, развившейся на фоне кровопотери, непосредственно после кровотечения количество ретикулоцитов повышается, что является важным признаком кровотечения. Количество лейкоцитов имеет нерезко выраженную тенденцию к снижению. Лейкоцитарная формула мало изменена. Количество тромбоцитов остается нормальным, а при кровотечениях несколько повышено

Пример гемограммы при железодефицитной анемии Эритроциты – 1. 1. 10. 12/л, Нв - 87 г/л, ЦП - 0. 55, Лейкоциты - 2. 10. 9/л, п/я - 2%, с/я - 67%, лимф - 30%, м - 1%, СОЭ 34 мм/час Тромбоциты – 200. 10. 9/л Эритроциты – 2. 2. 10. 12/л, Нв - 74 г/л, ЦП - 0. 65, Лейкоциты - 4. 10. 9/л, ретикулоциты 1%, п/я - 2%, с/я - 66%, лимф - 30%, м - 1%, СОЭ 34 мм/час

Диагностика при железодефицитной анемии Миелограмма: эритробластическая реакция с задержкой созревания и гемоглобинизации эритробластов на уровне полихроматофильного нормоцита. Костный мозг в большинстве случаев гиперпластичен. Увеличивается соотношение клеток белого и красного ряда, количество последних преобладает. Эритробласты составляют 40 -60 % всех клеток, во многих из них появляются дегенеративные изменения в виде вакуолизации цитоплазмы, пикноза ядер, отсутствует цитоплазма (голые ядра). Лейкопоэз характеризуется некоторым увеличением количества незрелых гранулоцитов

Диагностика при железодефицитной анемии Уровень железа в сыворотке крови здоровых людей, определяемый по методу Henry, составляет 0, 7 - 1, 7 мг/л, или 12, 5 - 30, 4 мкмоль/л, при дефиците железа он снижается до 0, 1 - 0, 3 мг/л, или 1, 8 - 5, 4 мкмоль/л. Общая железосвязывающая способность плазмы крови (или общий трансферрин сыворотки) при железодефицитной анемии увеличивается (норма составляет 30, 6 - 84, 6 мкмоль/л). Около 1/3 (30 - 35%) всего количества трансферрина сыворотки связано с железом (показатель насыщения трансферрина железом). Остальное количество трансферрина свободно и характеризует скрытую железосвязывающую способность сыворотки крови. У больных с дефицитом железа процент насыщения трансферрином снижается до 10 - 20, при этом увеличивается скрытая железосвязывающая способность плазмы

Диагностика при железодефицитной анемии Для установления причин и факторов, сопутствующих развитию анемии, часто необходимы: • исследование кислотности желудочного сока. • исследование кала на наличие паразитов. • исследование кала на скрытую кровь и выделение с калом введенного внутривенно меченого 59 Fe для выявления возможной кровопотери из пищеварительного канала. • рентгенологическое исследование пищеварительного канала для выявления язвенной болезни, грыжи пищевого отверстия диафрагмы, расширенных вен пищевода, опухолей и других заболеваний. • гинекологическое обследование. • исследование прямой кишки для выявления язвенного колита, геморроя, опухоли

Диета при железодефицитной анемии Разнообразная диета, включающая мясные продукты: телятина, печень и продукты растительного происхождения: бобы, сою, петрушку, горох, шпинат, сушеные абрикосы, чернослив, гранаты, изюм, рис, гречневую крупу, хлеб

Диета при железодефицитной анемии

Диета при железодефицитной анемии

Диета при железодефицитной анемии

Лечение при железодефицитной анемии Препараты железа: 1. Таблетированные 2. Парентеральные (феррум - лекк вв или вм) Какие показания к парентеральному введению препаратов?

Гемограмма при В 12 - дефицитной анемии

Описание гемограммы В гемограмме имеется: 1. Макросфероцитоз 2. Гиперхромия 3. В центре слайда МЕГАЛОБЛАСТ 4. Малое количество эритроцитов в препарате 5. Тельца Жолли и кольца Кебота

клиническая картина В 12 -дефицитной анемии • Анемический (циркуляторногипоксический) • Гастрологический • Неврологический • Гематологический

Гастроэнтерологический синдром Снижение аппетита, отвращение к мясу, боли и жжение на кончике языка, области десен, губ, чувство тяжести в эпигастрии после еды, отрыжку воздухом и съеденной пищей, чередование запоров и поносов, субфибрилитет, иногда боль и жжение в области прямой кишки. Об-но: увеличение печени, селезенки, синдром мальбсорбции. При исследовании желудочного сока– гистаминоустойчивая ахилия, при эндоскопии атрофия слизистой оболочки желудка. Воспалительно - атрофические изменения слизистой оболочки полости рта, языка, глоссит (гладкий «лакированный или полированный» язык с атрофированными сосочками, потрескавшийся, с участками воспаления ярко - красного цвета, местами с изъязвлением)

Неврологический синдром Наблюдается фуникулярный миелоз, поражение задних и боковых столбов спинного мозга, наступает демиелизация, а затем дегенерация нервных волокон в спинном мозге и спиномозговых нервах, вследствие нарушения распада жирных кислот, образование токсичных метилмалоновой и пропионовой кислот, ощущение онемения, «ватные ноги» . Поражение задних стволов сопровождается нарушением глубокой, пространственной, вибрационной чувствительности, сенсорной атаксией, затруднением при ходьбе, снижением сухожильных рефлексов, атрофией мышц нижних конечностей, нарушением функции тазовых органов (недержание мочи, кала). Поражение боковых стволов проявляется: нижним спастическим парапарезом с резким повышением сухожильных рефлексов и тонуса мышц нижних конечностей, дисфункцией тазовых органов (задержка мочеиспускания и дефекации), нарушение обоняния, слуха, психическими расстройствами, нарушением функции верхних конечностей. Об - но: нарушение глубокой чувствительности, нижний спастический парапарез, нарушение функции тазовых органов

Пример гемограммы при В 12 -дефицитной анемии Эритроциты – 1. 4. 10. 12/л, Нв - 67 г/л, ЦП - 1. 1, Лейкоциты - 4. 10. 9/л, п/я - 2%, с/я - 67%, лимф - 30%, м - 1%, СОЭ 26 мм/час Макроцитоз, отсутствие ретикулоцитов, кольца Кебота, тельца Жоли. Эритроциты – 1. 1. 10. 12/л, Нв - 57 г/л, ЦП - 1. 15, Лейкоциты - 4. 10. 9/л, п/я - 2%, с/я - 67%, лимф - 30%, м - 1%, СОЭ 36 мм/час Макроцитоз, отсутствие ретикулоцитов, кольца Кебота, тельца Жоли,

Миелограмма при В 12 -дефицитной анемии В стернальном пунктате – мегалобластический тип кроветворения , трехростковая цитопения (уменьшается синтез клеток эритроидного, гранулоцитарного и тромбоцитарного ростка)

Диагностика при В 12 -дефицитной анемии Изменения биохимических показателей: повышение в крови содержания сывороточного железа и гипербилирубинемия за счет непрямой его фракции. Можно определить низкое содержание витамина В 12 в крови (ниже 150 пг/мл при радиоиммунологическом методе). К дополнительным критериям относится: обнаружение антител к париетальным клеткам желудка, к гастромукопротеину или комплексу витамина В 12 + белок «R» , положительный результат теста Шеллинга (с применением витамина В 12, меченного Со 60) для оценки всасывания витамина В 12 в кишечнике в присутствии гастромукопротеиа или без него, повышенное в десятки раз выделение с мочой метилмалоновой кислоты (в норме 3. 5 мг/сут)

Этиология и патогенез при В 12 -дефицитной анемии В 12 - дефицитная анемия развивается в результате недостатка в организме антианемического фактора, необходимого для нормального созревания эритроцитов. Внешним фактором и является витамин В 12, заболевание может развиться при нарушении всасывания витамина В 12 (заболевания желудка, тонкой кишки, глистная инвазия), утилизации витамина В 12 костным мозгом или при повышенном расходовании витамина В 12 (беременность)

Лечение при В 12 -дефицитной анемии Витамин В 12 вм

Гемограмма при апластической анемии

Клиническая картина при апластической анемии Апластическая анемия может начаться остро и иметь быстро прогрессирующее течение, но чаще болезнь развивается постепенно. Клинические проявления зависят от выраженности цитопении. В клинической картине можно отметить следующие синдромы: - интоксикационный синдром; - анемический синдром; - геморрагический синдром; - септико - некротический синдром (пневмонии, абсцессы, фурункулы); - гиперпластический синдром в случае присоединения смешанного гемолиза (внутрисосудистого, внутриклеточного)

Геморрагический синдром при апластической анемии Геморрагический синдром соответствует степени тромбообразования. Наблюдаются петехиальные высыпания на коже и слизистых оболочках, кровоточивость десен, носовые и маточные кровотечения

Септико - некротический синдром при апластической анемии Следствием нейтропении являются инфекционные осложнения: ангины, некротические проявления на слизистых рта, желудочно - кишечного тракта, пневмонии, инфекции мочевых путей, сепсис

Апластическая анемия (гемограмма) Картина периферической крови: выраженная анемия (концентрация гемоглобина может падать до 20 - 30 г/л), лейкопения (нейтропения с относительным лимфоцитозом) и тромбоцитопения, иногда до полного исчезновения тромбоцитов из крови (панцитопения - снижение всех показателей периферической крови). Анемия чаще нормохромная, макроцитарная отмечается примерно у 60 - 65% больных, число ретикулоцитов снижено. Содержание железа в сыворотке крови нормальное или повышенное, насыщение трансферрина близко к 99%. СОЭ обычно увеличена до 40 - 60 мм/час Эритроциты – 1. 1. 10. 12/л, Нв - 87 г/л, ЦП - 0. 85, Лейкоциты - 2. 10. 9/л, п/я - 2%, с/я 67%, лимф - 30%, м - 1%, СОЭ 34 мм/час Тромбоциты – 20. 10. 9/л Эритроциты – 2. 2. 10. 12/л, Нв - 74 г/л, ЦП - 0. 9, Лейкоциты - 4. 10. 9/л, п/я - 2%, с/я - 67%, лимф - 30%, м - 1%, СОЭ 34 мм/час , Тромбоциты – 20. 10. 9/л

Миелограмма при апластической анемии

Миелограмма при апластической анемии При пункционной биопсии костного мозга (в миелограмме) отмечается малое количество ядросодержащих клеток (миелокариоцитов) или они совсем отсутствуют (трехростковая панцитопения), при гистологическом исследовании отмечаются замещение жиром деятельного костного мозга пунктат костного мозга - трехростковая панцитопения, жировая гиперплазия; культивирование костного мозга и изучение КОЕк; трепанобиопсия — замещение жиром деятельного костного мозга; признаки сосудистого и клеточного гемолиза

Лечение при апластической анемии Комплексная терапия и настойчивое продолжительное ее применении нередко в течение многих месяцев: - Гемотрансфузии компонентов крови (эр. масса; лейкомасса, тромбомасса). - Глюкокортикоиды (преднизолон), иногда продолжительностью до 4 - 6 месяцев. - Антибактериальная терапия. - Анаболические стероиды. - Витаминотерапия. - Сосудоукрепляющие средства. - Трансплантация аллогенного костного мозга. В последние годы применяют терапию колониестимулирующими факторами (КСФ). - препараты гранулоцитарного КСФ (Г - КСФ) филграстим, ленограстим, нартограстим преимущественно стимулируют образование нейтрофилов, - препараты гранулоцитарно –макрофагального КСФ (ГМ - КСФ): молграмостим, сарграмостим, лейкомакс стимулируют продукцию эозинофилов, нейтрофилов, моноцитов. - КСФ применяется в сочетании с интерлейкинам

Лечение при апластической анемии При неэффективности описанной терапии применяется хирургическое лечение - спленэктомия. Показания: - отсутствие эффекта от консервативной терапии, - отсутствие геморрагического синдрома, - светлый промежуток. - КОЕк > 25 • 105 миелокариоцитов. После спленэктомии показано лечение анаболическими гормонами: неробол по 20 мг/сут. , ретаболил по 200 мг/сут. , в течение 5 - 6 месяцев. После операции состояние ряда больных значительно улучшается. Повышение показателей крови начинается через 2 - 5 мес. Одним из основных методов лечения тяжелой апластической анемии остается трансплантация костного мозга от доноров, подобранных по системе HLA

Гемограмма при гемолитической анемии 1. 1 1. 2 5 3 4

Гемограмма при гемолитической анемии • 1. Серповидноклеточная анемия, талассемия • 2. Наследственный микросфероцитоз • 3. 4. 5 Аутоиммунные

Описание гемограммы при гемолитической анемии В гемограмме имеется: 1. Микросфероцитоз 2. Гипохромия 3. Мешеневидный эритроциты 4. Серповидноклеточные эритроциты

Гемолитическая анемия

Гемолитическая анемия (аутоиммунная)

Врожденная анемия

Гемолитические анемии Гемолитические анемии - это группа заболеваний, при которых уменьшается средняя продолжительность жизни эритроцитов. В большинстве случаев костный мозг функционирует нормально; возможно образование адекватного числа новых эритроцитов, с повышением числа ретикулоцитов. Гемолитические анемии - группа наследственных и приобретенных заболеваний, характеризующихся повышенным внутриклеточным (гемолиз в клетках фагоцитарной системы) или внутрисосудистым (гемолиз в сосудистом русле при участии комплемента) разрушением эритроцитов. Диагностические признаки заболевания обусловлены: - ускоренным распадом эритроцитов (уменьшение времени жизни эритроцитов, повышение содержания сывороточного ЛДГ, восстановленного гаптоглобина), - увеличением активности костного мозга (эритроидная гиперплазия, ретикулоцитоз)

Гемолитические анемии Анемии вследствие усиленного кроверазрушения (гемолитические): - наследственные: 1) связанные с нарушением структуры мембраны эритроцитов (микросфероцитоарная анемия Миньковского – Шаффара, овалоцитоз, акантоцитоз), 2) связанные с дефицитом ферментов в эритроцитах, 3) связанные с нарушением синтеза гемоглобина (серповидноклеточная анемия, гемоглобинозы, талассемия) - приобретенные: 1) аутоиммунные, 2) пароксизмальная ночная гемоглобинурия, 3) лекарственные, 4) травматические и микроангиоспастические, 5) вследствие отравления гемолитическими ядами и бактериальными токсинами. - анемии смешанные

Гемолитические анемии делятся на иммунные и неиммунные. К неиммунным гемолитическим анемиям относятся: 1. Врожденные. - мембранопатии (наследственный микросфероцитоз, овалоцитоз, стоматоцитоз, эллиптоцитоз, пиропойкилоцитоз). - ферментопатии (дефицит в эритроцитах ферментов Г- 6 ФД и глутатионредуктазы). - гемоглобинопатии (талассемии и различные варианты носительства нестабильного Нb). 2. Приобретенные гемолитические анемии

Классификация гемолитических анемий в зависимости от локализации гемолиза (Besa et al. 1992) • внутриклеточный гемолиз, • внутрисосудистый гемолиз

Гемолитические анемии Внутриклеточный гемолиз происходит в основном в селезенке при гиперспленизме, в результате чего усиливается фильтрационно – гемолитическая функция селезенки. Эритроциты секвестрируются в ее паренхиме, сокращается их продолжительность жизни, активизируются процессы утилизации образующегося из гемоглобина билирубина. Часто наблюдается при гиперспленизме лейкопения и тромбоцитопения. Гемолитические анемии (внутриклеточный гемолиз), обусловленные дефектами метаболизма эритроцитов (недостаточность пируваткиназы, пиримидин – 5 нуклеотидазы, тяжелая гипофосфатемия), болезнь нестабильного гемоглобина

Гемолитические анемии (внутриклеточный гемолиз): - аутоиммунные гемолитические анемии, - гемолитические анемии, обусловленные дефектами мембраны эритроцитов (наследственный сфероцитоз и др. дефекты). Наиболее вероятную основу АИГА составляет срыв иммунологической толерантности. Развивается дисбаланс в соотношении Т - хелперов и Т - супрессоров со снижением активности последних. В результате активируются Т - лимфоциты хелперы и В – лимфоциты и создаются благоприятные условия для продукции аутоантител, которые чаще относятся к классу Ig. G. Эти антитела связываются в присутствии СЗ - конвертазы комплемента с антителами мембраны эритроцитов, с последующим образованием конечного активирующего комплекса С 56789, и реализацией внутрисосудистого механизма гемолиза. Наследственные гемолитические анемии, обусловленные нарушением синтеза гемоглобина: талассемия, серповидно – клеточная анемия, гемоглобинозы. Талассемия – заболевание, связанное с нарушением скорости синтеза одного вида цепей глобина, различают: - а – талассемию, - β – талассемию, - γ - талассемию

Гемолитические анемии (лечение) Глюкокортикоидная терапия. - при острых формах назначается преднизолон в дозе 60 – 80 – 150 мгсут и более. Суточная доза в 3 приема в пропорции 3: 2: 1. - по мере уменьшения проявлений криза доза постепенно снижается по 2. 5 – 5 мг в день до половины исходной. Далее она снижается на 2. 5 мг каждые 4 – 5 дней, затем еще меньшими дозами с большими интервалами, после чего отменяют. - при хронической аутоиммунной гемолитической анемии с неполными тепловыми агглютининами преднизолон применяют в суточной дозе 20 – 40 мг, а затем – поддерживающая доза (5 – 10 мг в день). Лечение эффективно у 80% больных, но рецидивы наступают часто. При хронической аутоиммунной гемолитической анемии с неполными тепловыми агглютининами преднизолон применяют в суточной дозе 20 – 40 мг, а затем – поддерживающая доза (5 – 10 мг в день). Лечение эффективно у 80% больных, но рецидивы наступают часто. - применяют иммунодепрессанты - хлорбутил, - плазмаферез, - иммуноглобулин G 0. 5 – 1 г/кг/сут в/в в течение 5 суток

Гемолитические анемии (лечение) Хирургическое лечение: - спленоэктомия применяется больным, вынужденным более 4 – 5 месяцев постоянно принимать преднизолон, имеющим частые рецидивы в течение года или перерывы в лечении преднизолоном не превышают 2 месяцев. спленэктомия дает положительный результат у 60% больных. - эмболизация сосудов селезенки, без операции выключает селезенку из общего кровотока. Цитостатическая терапия блокирует образование антител к эритроцитам, назначается при отсутствии эффекта от кортикостероидной терапии и спленоэктомии. Назначается азатиоприн (имуран) в суточной дозе 100 – 150 мг, циклофосфамид в дозе 400 мг в день, винкристин по 2 мг 1 раз в неделю, хлорбутин в суточной дозе 2. 5 – 5 мг. Лечение проводится до уменьшения гемолиза, чаще всего с преднизолоном, затем назначается поддерживающая доза (1/2 первоначальной). Курс лечения до 2 – 3 месяцев
Анемия при талассемии
Наследственный микросфероцитоз

Лейкоцитарная формула

Гемобластозы 1 уровень Онкогематология является одной из самых динамичных областей медицины, которая особенно активно развивалась в последние годы. Полученные, с помощью современных молекулярно-биохимических методов, результаты позволили объяснить структурные изменения генома клетки, ответственные за возникновение и темпы роста опухоли. Молекулярные исследования измененных участков хромосом привели к открытию генов, участвующих в развитии опухоли. Значительно расширены и уточнены представления о роли цитокинов в кроветворении. Изменились взгляды на патогенез лейкозов, изучены этапы дифференцировки нормальных кроветворных клеток и кроветворных клеток при лейкозах, что позволяет судить об уровне, на котором произошла малигнизация. Гемобластозы - это опухолевый процесс, (новообразования), возникающий из клеток кроветворной ткани. Все лейкозы, как острые, так и хронические, имеют клоновый характер роста, то есть происходят из одной клетки, подвергшейся мутации. Скорость развития процесса зависит от доли активно пролиферирующих клеток, скорости гибели клеток и других факторов. Первичный лейкозный клон обладает генетической нестабильностью, в силу чего подвержен опухолевой прогрессии. Гемобластозы подразделяются на 2 группы: 1) системные заболевания, диффузно поражающие кроветворную ткань - лейкозы; 2) регионарные заболевания лимфомы, которые образуют солидные опухоли

Гемобластозы Лейкозы - полиэтиологические заболевания. В возникновении их могут быть повинны различные факторы, способные вызвать мутацию клеток кроветворной системы. Среди мутагенов следует назвать: - вирусы, - ионизирующее излучение (частота мутаций зависит непосредственно от дозы ионизирующей радиации. После атомного взрыва в Хиросиме и Нагасаки заболеваемость острым лейкозом и хроническим миелозом среди облученных возросла примерно в 7, 5 раз ), - ряд химических веществ (дибензантрацен, бензпирен, метилхолантрен, т. е. бластомогенные вещества). - «программированная клеточная смерть» или «апоптоз»

Причины развития острых лейкозов

классификация лейкозов (ВОЗ 2001 год) ОПУХОЛИ ИЗ ПРЕДШЕСТВЕННИКОВ В - ЛИМФОЦИТОВ I. В-лимфобластный лейкоз/лимфома из предшественников В-клеток (острый лимфобластный лейкоз из предшественников В-клеток), II. Зрелые В-клеточные опухоли с фенотипом зрелых лимфоцитов) • Хронический лимфоцитарный лейкоз/лимфома из малых лимфоцитов • В-клеточный пролимфоцитарный лейкоз • Лимфоплазмоцитарная лимфома • Селезеночная лимфома маргинальной зоны • Волосатоклеточная лейкоз • Плазмоцитарная миелома • Моноклональная гаммапатия с неопределенным потенциалом • Солитарная плазмоцитома костей • Внекостная плазмоцитома

классификация лейкозов (ВОЗ 2001 год) • Первичный амилоидоз • Болезнь тяжелых цепей • Экстранодальная В - клеточная лимфома маргинальной зоны (лимфома лимфоидной ткани, ассоциированной со слизистыми оболочками; MALT - лимфома) • Нодальная В - клеточная лимфома маргинальной зоны • Фолликулярная лимфома • Лимфома из клеток зоны мантии • Диффузная крупноклеточная В - клеточная лимфома • Медиастинальная крупноклеточная В - клеточная лимфома • Внутрисосудистая крупноклеточная В - клеточная лимфома • Первичная лимфома серозных полостей • Лимфома/лейкоз Беркитта

классификация лейкозов (ВОЗ 2001 год) III. В-клеточные лимфопролиферативные процессы с неопределенным опухолевым потенциалом 1. Лимфоматоидный гранулематоз 2. Посттрансплантационное лимфопролиферативное заболевание, полиморфноклеточное Т-КЛЕТОЧНЫЕ ОПУХОЛИ I. Опухоли из предшественников Т-лимфоцитов Т-лимфобластный лейкоз/лимфома из предшественников Т-клеток (острый лимфобластный лейкоз из предшественников Т-клеток). II. Т- и NK-клеточные опухоли с фенотипом зрелых лимфоцитов Лейкозы и первично диссеминированные лимфомы: 1. Т-клеточный пролимфоцитарный лейкоз 2. Т-клеточный лейкоз из крупных гранулярных лимфоцитов 3. Агрессивный NK-клеточный лейкоз 4. Т-клеточный лейкоз/лимфома взрослых Кожные лимфомы 1. Грибовидный микоз 2. Синдром Сезари 3. Первичная кожная крупноклеточная анапластическая лимфома 4. Лимфоматоидный папуллез

классификация лейкозов (ВОЗ 2001 год) III. Другие экстранодальные лимфомы 1. Экстранодальная NK/Т-клеточная лимфома, назальный тип 2. Т-клеточная лимфома типа энтеропатии 3. Гепатолиенальная Т-клеточная лимфома 4. Панникулитоподобная Т-клеточная лимфома подкожной клетчатки. IV. Лимфомы лимфатических узлов 1. Ангиоиммунобластная Т-клеточная лимфома 2. Лимфома из клеток с иммунофенотипом периферических Тлимфоцитов, неуточненная 3. Анапластическая крупноклеточная лимфома V. Опухоль неопределенной дифференцировки 1. Бластная NK-клеточная лимфома. ЛИМФОМА ХОДЖКИНА Нодулярный тип лимфоидного преобладания II. Классическая лимфома Ходжкина 1. Нодулярный склероз 2. Смешанно-клеточный вариант 3. С большим количеством лимфоцитов 4. С истощением лимфоидной ткани

Острые лейкозы Острые лейкозы представляют собой гетерогенную группу опухолевых заболеваний системы крови - гемобластозов, которые характеризуются первичным поражением костного мозга морфологически незрелыми кроветворными (бластными) клетками с вытеснением ими нормальных элементов гемопоэза и инфильтрацией ими различных тканей и органов. Острые лейкозы - клональные (онкологические) заболевания, первично возникающие в костном мозге в результате мутации стволовой клетки крови. Следствием мутации является потеря потомками мутировавшей клетки способности к дифференцировке до зрелых клеток крови. Клеточным (морфологическим) субстратом острых лейкозов являются бластные клетки. Острые лейкозы – это довольно редкое заболевание и составляет лишь 3% злокачественных опухолей человека. Однако среди гемобластозов острые лейкозы занимают одно из первых мест по частоте встречаемости. При правильном и своевременном лечении прогноз для детей часто благоприятен. Как для опухолевых заболеваний, для острых лейкозов невозможно выделить специфический этиологический фактор. Среди мутагенов следует назвать вирусы, ионизирующее излучение, ряд химических веществ. Среди острых лейкозов чаще встречаются острый миелобластный и лимфобластный лейкозы


Маски острых лейкозов

Острые лейкозы Различают стадии острого лейкоза: 1. Начальная-оценивается ретроспективно. 2. Развернутый период с клиническими и гематологическими проявлениями. Здесь различаются: а) первая атака; б) рецидив болезни; в) второй рецидив и т. д. ; г) ремиссия. Признаки полной клинико-гематологической ремиссии: нормализация общего состояния больного; наличие в миелограмме не более 5% бластных клеток; в крови лейкоцитов не менее 5. 109/л; тромбоцитов не менее 100. 109/л; бластных элементов в периферической крови нет. Выздоровление - это полная клинико-гематологическая ремиссия на протяжении 5 и более лет, 3. Терминальная - отсутствие эффекта от цитостатической терапии, угнетение нормального кроветворения Различаются 2 фазы болезни: а) алейкемическая (без выхода бластов в периферическую кровь); 6) лейкемическая (с выходом бластных клеток в периферическую кровь). Клиническая картина одинакова для всех типов острых лейкозов. Начало заболевания может быть внезапным. Тяжёлое состояние больного может быть обусловлено выраженной интоксикацией, геморрагическим синдромом (результат тромбоцитопении), дыхательной недостаточностью (вследствие сдавления дыхательных путей увеличенными внутригрудными лимфатическими узлами)

Клиническая картина острых лейкозов

Клиническая картина острых лейкозов (синдромы) • Анемический синдром: бледность, одышка, сердцебиение, сонливость. • Инфекционно-некротический синдром (склонность к инфекциям бактериальным, грибковым и вирусным). • Геморрагический синдром. При осмотре выявляют петехии и экхимозы на коже (самопроизвольные, в местах инъекций, механического трения). Возможны интенсивные носовые и тяжёлые внутренние кровотечения (метроррагии, желудочно-кишечные кровотечения, кровоизлияния в мозг). • Гиперпластический синдром (лимфаденопатия): лимфатические узлы множественные, плотные, эластичные, округлые, могут быть спаяны друг с другом, разных размеров (от 1 до 8 см); их пальпация безболезненна, увеличение брыжеечных лимфатических узлов, гипертрофия червеобразного отростка, гипертрофия внутригрудных лимфатических узлов. Печень и селезёнка увеличены. Гипертрофия дёсен, лейкемиды кожи (специфические узелки). В средостение наблюдается гипертрофия тимуса, что может вызвать сдавление органов средостения)

Клиническая картина острых лейкозов Признаки специфического поражения: • Интоксикация: лихорадка, снижение массы тела, снижение аппетита, слабость, усиленная потливость. • Болезненность костей (особенно трубчатых, позвоночника), артралгии. • ДВС-синдром. • Нейролейкемия. (поражение центральной нервной системы) возникает особенно часто при остром лимфобластном лейкозе и значительно ухудшает прогноз. Возникновение нейролейкемии обусловлено метастазированием лейкозных клеток в оболочки головного и спинного мозга или в вещество мозга (интратумор, прогностически более тяжёлый тип опухолевого роста). В неврологическом статусе возможны проявления различной тяжести - от лёгкой общемозговой симптоматики (головная боль) до очаговых поражений (нарушение сознания, нарушение зрения, дискоординация движений, дисфазия)


Клиническая картина острых лейкозов

Острый миелобластный лейкоз Заболевание характеризуется прогрессирующим течением, выраженной интоксикацией и лихорадкой, рано наступающей клинико -гематологической декомпенсацией процесса в виде тяжелой анемии, умеренной интенсивностью геморрагических проявлений, частных язвенно-некротических поражений слизистых и кожи. Основными молекулярными проявлениями, ведущими к формированию лейкемического клона при миелоидных лейкозах, являются либо возникновение специфических транслокаций, как правило, с вовлечением протоонкогенов, либо мутации генов, участвующих в контроле пролиферации и дифференцировки миелоидной ткани. Для миелоидных опухолей наиболее характерными являются реципрокные транслокации, при которых происходит обмен генетическим материалом между различными хромосомами с образованием патологических хромосомных структур. Самой известной из этих хромосом является Филадельфийская хромосома

Острый миелобластный лейкоз В периферической крови и костном мозге преобладают миелобласты

Острый миелобластный лейкоз

Острый лимфобластный лейкоз чаще встречается у детей и у лиц молодого возраста. Характеризуется увеличение какой-либо группы лимфоузлов, селезенки. Самочувствие больных не страдает, интоксикация выражена умеренно, анемия незначительная. Геморрагический синдром часто отсутствует. Больные жалуются на боли в костях. Острый лимфобластный лейкоз отличается частотой неврологических проявлений (нейролейкемия). В периферической крови и в пунктате присутствуют лимфобласты (молодые крупные клетки с округлым ядром)

Верификация диагноза должна основываться на следующей картине: цитоморфологической (выявление бластов), цитохимической, цитогенетической на иммунофенотипировании бластных клеток (выявление кластеров дифференцировки (СД-маркеров)

Диагностика острых лейкозов Анализ крови: нормохромная нормоцитарная анемия; количество лейкоцитов может быть различным низким (ниже 5. 109/л), нормальным (от 5. 109/л до 20. 109/л. ), повышенным (свыше 20. 109/л. , достигая в некоторых случаях 200. 109/л); нейтропения (не зависит от общего количества лейкоцитов); абсолютный лимфоцитоз; тромбоцитопения (присутствует почти всегда); «лейкемический провал» , что означает присутствие бластов, зрелых форм на фоне отсутствия промежуточных форм; при остром миелобластном лейкозе можно обнаружить азурофильные гранулы и палочки Ауэра. Лейкопенический вариант острого лейкоза встречается почти у 50% больных Общий анализ крови Эритроциты – 1. 1. 10. 9/л, Нв - 87 г/л, ЦП - 0. 8, Лейкоциты - 2. 10. 9/л, бласты - 82%, лимф - 16%, м - 2%, СОЭ 54 мм/час Тромбоциты – 20. 10. 9/л Эритроциты – 1. 1. 10. 9/л, Нв - 87 г/л, ЦП - 0. 8, Лейкоциты - 28. 10. 9/л, бласты - 76%, лимф - 12%, м - 2%, СОЭ 74 мм/час Тромбоциты – 60. 10. 9/л

Острые лейкозы (морфологический метод)

Диагностика острых лейкозов Миелограмма (количественное определение всех клеточных форм костного мозга) получается при стернальной пункции или трепанобиопсии подвздошной кости: увеличение содержания бластных клеток от 20% и до тотального бластоза. Морфология бластов различна в зависимости от типа лейкоза. Отмечается увеличение промежуточных форм, лимфоцитоз, красный росток кроветворения угнетён (за исключением острого эритромиелоза), мегакариоциты отсутствуют или их количество незначительно (за исключением острого мегакариобластного лейкоза)

Диагностика острых лейкозов Цитохимическое исследование - основной метод диагностики форм острых лейкозов. Его проводят с целью выявления ферментов, специфических для различных бластов. Цитохимические методы представляют собой достаточно простые, хорошо воспроизводимые, не требующие сложной аппаратуры методики, которые могут быть освоены в любой лаборатории. Монобластная форма лейкоза: Пероксидаза слабо + или отрицат, Липиды слабо + или отрицат, PAS-реакция + мелкогрануллированная , Неспецифическая эстераза +, Хлорацетат Эстераза _, Кислая фосфатаза + Промиелоцитарная форма лейкоза: Пероксидаза слабо + или отрицат, Липиды слабо + или отрицат, PAS-реакция + диффузная , Неспецифическая эстераза +, Хлорацетат Эстераза _, Кислая фосфатаза +

Основные цитохимические характеристики бластных клеток при острых лейкозах Лимфобластная форма лейкоза: Пероксидаза -, Липиды -, PAS-реакция + крупногрануллированная, Неспецифическая эстераза -, Хлорацетат Эстераза -, Кислая фосфатаза в отдельных клетках Промиелоцитарная форма лейкоза: Пероксидаза слабо + или отрицат, Липиды слабо + или отрицат, PAS-реакция + диффузная , Неспецифическая эстераза +, Хлорацетат Эстераза _, Кислая фосфатаза + Миелобластная форма лейкоза: Пероксидаза +, Липиды +, PAS-реакция + диффузная, Неспецифическая эстераза слабо +, Хлорацетат Эстераза +, Кислая фосфатаза + Недифференцированная форма лейкоза: Пероксидаза отрицат, Липиды слабо отрицат, PAS-реакция отрицат, Неспецифическая эстераза отрицат, Хлорацетат Эстераза отрицат, Кислая фосфатаза отрицат

Диагностика острых лейкозов Иммунофенотипирование бластов проводят автоматизированным методом на проточном цитофлюориметре или иммуноферментным методом на стекле с использованием световой микроскопии. Последний имеет то преимущество, что его можно проводить параллельно с цитохимическим исследованием. Иммунофенотипирование позволяет определить с помощью моноклональных антител наличие или отсутствие кластеров дифференцировки бластных клеток (CD - маркёры). Его проведение в первую очередь необходимо для точной диагностики острого лимфолейкоза, а также в трудных случаях дифференциальной диагностики острых лимфобластных и миелобластных лейкозов

Лечение острых лейкозов Основные направления терапии • Специфическая химиотерапия направлена на достижение и закрепление ремиссии заболевания, состоит из нескольких этапов, различна для лимфобластного и миелобластного лейкозов. Расчёт доз производят на площадь поверхности тела по таблице Дюбуа с учётом массы тела и роста. • Сопутствующая терапия. Её проводят для борьбы с инфекциями, обусловленными агранулоцитозом, для снижения интоксикации при лизисе опухолевого субстрата, для уменьшения побочных токсических эффектов химиотерапевтических препаратов. • Заместительная терапия необходима при угрожающей тромбоцитопении, тяжёлой анемии, нарушениях свертывания крови. • Трансплантация стволовых кроветворных клеток или костного мозга. Лечение химиотерапевтическими препаратами начинают после установления типа (лимфобластный, миелобластный) и варианта острого лейкоза. Все острые лейкозы лечатся индивидуально по строго соблюдаемым протоколам (программам) полихимиотерапии, которые создаются на основе результатов исследований объединенных гематологических научных групп в различных странах. Лечение миелобластного и лимфобластного лейкозов различное

Лечение острого лимфобластного лейкоза Лечение острого лимфобластного лейкоза проводят соответственно его иммунофенотипическому варианту, данных цитогенетики. Протоколы лечения обязательно включают в свой состав Lаспарагиназу в сочетании с винкристином, рубомицином, циклофосфамидом, цитарабином, меркаптопурином, преднизолоном, а также применяют 6 люмбальных пункций с введением метотрексата, преднизолона и цитарабина. Для применения того или иного протокола лечения, выделяют группы стандартного и высокого риска острого лимфобластного лейкоза. Сроки лечения и дозы препаратов зависят также от стадии (индукция ремиссии, консолидация – закрепление, редукция ремиссии, поддерживающая терапия). В группе высокого риска лечение длительное, большими дозами и поддерживающая терапия не проводится

Лечение острого миелобластного лейкоза Программой лечения острого миелобластного лейкоза является « 7+3» - «золотой стандарт» полихимиотерапии. Индукция ремиссии: цитарабин 7 дней + рубомицин 3 дня (два курса), консолидация ремиссии: 2 курса « 7+3» , Поддерживающая: « 7+3» с интервалом в 6 недель

Лечение острых лейкозов Трансплантация костного мозга успешно используется для лечения пациентов с лейкозом, апластической анемией, лимфомами (лимфома Ходжкина, множественная миелома, иммунная недостаточность, нейробластомы), и при некоторых солидных опухолях (рак груди и рак яичников). Здоровые стволовые клетки пересаживаются реципиенту для возобновления нормального функционирования системы кроветворения. Трансплантация костного мозга, несмотря на название, на самом деле является трансплантацией стволовых клеток костного мозга. Пересадка костного мозга является очень интенсивным методом лечения, поэтому возраст пациента и общее состояние здоровья должны приниматься во внимание при решении вопроса трансплантации. К примеру, обычно пациент должен не старше 65 лет для прохождения такого лечения

Хронические лейкозы Морфологический субстрат хронических лейкозов - это относительно дифференцированные клетки кроветворной ткани. Больные могут жить без лечения в течение нескольких месяцев и лет. Хронические лейкозы нередко трансформируются в острые формы. В группу хронических лейкозов входят дифференцирующиеся опухоли системы крови, исходящие из костного мозга. Основной субстрат этих лейкозов составляют морфологически зрелые клетки. Хронические лейкозы подразделяют на миелоидные (хронический миелолейкоз), лимфоидные (хронический лимфолейкоз и волосатоклеточный лейкоз), моноцитарные (миеломоноцитарные), эритроцитарные (истинная полицитемия) и мегакариоцитарные

Хронический миелолейкоз – опухоль, возникающая из ранних клеток, предшественниц миелопоэза, дифференцирующихся до зрелых форм. При хроническом миелолейкозе морфологическим субстратом опухоли являются активно пролиферирующие дифференцирующиеся и зрелые клетки гранулоцитарного ряда. В структуре заболеваемости гемобластозами хронический миелолейкоз занимает пятое место (8, 9% случаев). Нестандартизованный среднегодовой показатель заболеваемости на 100 000 населения составляет 1 случай. Он диагностируется редко в детском и юношеском возрасте, хронический миелолейкоз одинаково часто встречается среди мужчин и женщин, болеют обычно люди в возрасте 30 -70 лет, в детском и юношеском возрасте заболевание встречается редко. Возрастной пик приходится на 40 - 50 лет. Среди больных отмечено небольшое преобладание мужчин. В большинстве случаев (80 - 88%) хронического миелолейкоза выявляется хромосомный маркер опухолевого клона Ph'-хромосома, называемая филадельфийской, которая присутствует почти во всех клетках костного мозга гранулоцитах, моноцитах, эритрокариоцитах и мегакариоцитах, в лимфоцитах ее нет. Эта аномалия часто сочетается с трисомией 8, 9, 19, 21, делецией 5 и с другими дефектами хромосом. До 95% случаев хронический миелолейкоз Ph - позитивный и лишь 5% регистрируются как Ph - негативный. Хотя возникновение заболевания связано с изменением хромосомного материала, семейной предрасположенности не выявлено, также не установлена ассоциация с HLA генотипом

Клиническая картина при хроническом миелолейкозе (начальная стадия) Клиническая картина зависит от стадии заболевания. Выделяют 3 стадии хронического миелолейкоза: начальную, развернутую и терминальную (ВОЗ 2001 г. ). • В начальной стадии хронический миелолейкоз практически не диагностируется или выявляется при случайном исследовании крови, поскольку симптоматика в этот период почти отсутствует. Имеются жалобы на слабость, потливость, снижение аппетита, похудание, тошноту, повышение температуры тела, одышку, сердцебиение, боли в сердце, боли в костях, в левом или правом подреберье, увеличение периферических лимфатических узлов. Уже в этой стадии увеличивается селезенка, что вызывает неприятные ощущения в левом подреберье, чувство тяжести, особенно после еды. Практически эту стадию выделить не удается. Ведущий клинический симптом - спленомегалия как следствие миелоидной метаплазии (инфильтрации) селезенки

Диагностика при хроническом миелолейкозе (начальная стадия) В периферической крови: постоянный и немотивированный лейкоцитоз (40 -70. 109/л) с нейтрофильным профилем, сдвигом влево до миелоцитов. Важным гематологическим признаком является увеличение количества базофилов и эозинофилов различной зрелости. Анемия в этот период не наблюдается. Отмечается тромбоцитоз до 600 -1500. 109/л. Костный мозг: • гиперклеточный, Л/Э 10: 1 • увеличение миелокариоцитов происходит за счет незрелых и зрелых форм гранулоцитов • количество бластных клеток не превышает 5% • изредка эритробластоз • в 1/3 случаев - гиперплазия мегакариоцитов

Клиническая картина при хроническом миелолейкозе (развернутая стадия) Болезнь, как правило, диагностируется на стадии тотальной генерализации опухоли по костному мозгу, то есть в развернутой стадии. Развернутая стадия характеризуется появлением клинических признаков заболевания, связанных с лейкемическим процессом. При объективном исследовании почти постоянным признаком в этот период является увеличение селезенки, достигающей в ряде случаев значительных размеров. При пальпации селезенка остается безболезненной. Быстрый рост селезенки часто приводит к перисплениту и у половины больных инфарктам селезенки, проявляющиеся острыми болями в левом подреберье с иррадиацией в левый бок, левое плечо, усиливающейся при глубоком вдохе. Продолжительность этой стадии без цитостатической терапии составляет 1, 52, 5 года. Клиническая картина при лечении заметно изменяется. Самочувствие больных длительно остается удовлетворительным, сохраняется работоспособность, количество лейкоцитов около 10 - 20. 109/л, прогрессирующего увеличения селезенки не наблюдается. Развернутая стадия у больных, принимающих цитостатики, длится 4 - 5 лет, а иногда и больше

Диагностика при хроническом миелолейкозе (развернутая стадия) В периферической крови: анемия имеет нормохромный характер, нередко выражен анизо- и пойкилоцитоз. В лейкоцитарной формуле представлен весь гранулоцитарный ряд включительно до миелобластов (бластные клетки 5 -10%). Количество лейкоцитов достигает 250 -500. 109/л. Костный мозг: • гиперклеточный, Л/Э 20: 1 и более • число незрелых форм гранулоцитов повышается • количество эритро-кариоцитов уменьшается • содержание мегакариоцитов в норме

Гемограмма при хроническом миелолейкозе Общий анализ крови Эритроциты – 3. 1. 10. 9/л, Нв - 87 г/л, ЦП - 0. 8, Лейкоциты - 122. 10. 9/л, Базофилы – 8% Эозинофилы – 6% миелобласты – 0, 2%, промиелоциты – 10%, метамиелоциты – 8%, миелоциты – 12%, юные – 23%, п/я - 2%, с/я - 7%, лимф - 3%, м - 1%, СОЭ 34 мм/час Тромбоциты – 620. 10. 9/л Эритроциты – 3. 1. 10. 9/л, Нв - 87 г/л, ЦП - 0. 8, Лейкоциты - 122. 10. 9/л, миелобласты – 0, 1%, Базофилы – 6% Эозинофилы – 6% промиелоциты – 8%, метамиелоциты – 12%, миелоциты – 19%, юные – 24%, п/я - 2%, с/я - 7%, лимф - 17%, м - 1%, СОЭ 34 мм/час Тромбоциты – 320. 10. 9/л

Клиническая картина при хроническом миелолейкозе (терминальная стадия) В терминальной стадии отмечается резкое ухудшение общего состояния, усиление потливости, стойкое немотивированное повышение температуры. Появляются сильные боли в костях и суставах. Важным признаком является появление рефрактерности к проводимой терапии. Значительно увеличена селезенка. Нарастает анемия, тромбоцитопения. При умеренном повышении количества лейкоцитов формула омолаживается за счет увеличения процента незрелых клеток (промиелоцитов, миелобластов и недифференцируемых клеток). Геморрагический синдром, отсутствовавший в развернутой стадии, почти постоянно появляется в терминальном периоде

Клиническая картина при хроническом миелолейкозе (терминальная стадия) Опухолевый процесс в терминальной стадии начинает распространяться за пределы костного мозга: возникает лейкемическая инфильтрация нервных корешков, вызывающая радикулярные боли, образуются подкожные лейкемические инфильтраты (лейкемиды), наблюдается саркомный рост в лимфоузлах. Лейкемическая инфильтрация на слизистых оболочках способствует развитию в них кровоизлияний с последующим некрозом. В терминальной стадии больные склонны к развитию инфекционных осложнений, которые нередко являются причиной смерти

Клиническая картина при хроническом миелолейкозе В течении хронического миелолейкоза может наблюдаться развитие бластного криза. У больных отмечаются резкое ухудшение общего состояния, признаки интоксикации, лихорадка, боли в костях, метастазы в селезенку, печень, лимфатические узлы, кости, другие органы и ткани, анемия, геморрагии. В гемограмме и/или в костном мозге обнаруживается значительное количество миелобластов. В единичных случаях выявляются лимфобласты, что свидетельствует о поражении кроветворения на уровне полипотентной стволовой клетки. Диагностические признаки бластного криза хронического миелолейкоза: увеличение суммарного количества бластных клеток, промиелоцитов в периферической крови или костном мозге до 20% и более. С учетом морфологических, цитохимических, иммунофенотипических особенностей бластных клеток различают несколько вариантов бластного криза - миеломонобластный, миелобластный, лимфобластный, монобластный, промиелоцитарный, эритробластный, мегакариобластный

Диагноз при хроническом миелолейкозе Стадия хронического миелолейкоза устанавливается на основании комплекса клинических данных и изменений со стороны кроветворения с учетом данных гемограммы, миелограммы, гистологического исследования. Иногда недостаточно явная клинико-гематологическая картина на начальном этапе заболевания не позволяет уверенно поставить диагноз хронического миелолейкоза. В этих случаях важное значение для диагностики имеет обнаружение Ph'-хромосомы в гранулоцитах, моноцитах, эритро- и мегакариоцитах костного мозга (следует помнить о вариантах хронического миелолейкоза без Ph'хромосомы)

Лечение при хроническом миелолейкозе Лечение хронического миелолейкоза определяется стадией заболевания. В случаях слабо выраженных клинико-гематологических проявлений хронической стадии рекомендуют общеукрепляющую терапию, полноценное питание, богатое витаминами, регулярное диспансерное наблюдение. Имеются сведения о благоприятном влиянии на течение заболевания а-интерферона. Лечение хронического миелолейкоза в развернутой и терминальной стадии имеет свои отличия. В развернутой стадии терапия направлена на уменьшение массы опухолевых клеток и ставит своей целью сохранить как можно дольше соматическую компенсацию больных и отсрочить наступление бластного криза. Цитостатическая терапия начинается с момента установления диагноза. применяют моно- и полихимиотерапию. Препараты: - миелосан действует на стволовые кроветворные клетки, менее активен на клеткипредшественники отдельных ростков кроветворения и не действует на быстро пролиферирующие клетки, - гидроксимочевина (гидреа) влияет на пролиферирующие клетки, - интерфероны- «модификаторы биологического. - гливек – противоопухолевый препарат, ингибитор протеинтирозинкиназы - анормального фермента, продуцируемого филадельфийской хромосомой, подавляет пролиферацию, индуцируя их апоптоз, - новые ингибиторы тирозинкиназ: нилотиниб, дисатиниб. Лучевая терапия в качестве первичного лечения, особенно при спленомегалии, Лимфоцитаферез при резистентности к цитостатической терапии

Лечение при хроническом миелолейкозе Лечение в терминальной стадии хронического миелолейкоза при наличии бластных клеток в периферической крови проводят по схемам острого миелобластного лейкоза. ВАМП, ЦАМП, АВАМП, ЦОАП, сочетание винкристина с преднизолоном, цитозара с рубомицином. Терапия направлена на продление жизни больного, так как получить ремиссию в этом периоде трудно. При развитии бластного криза проводится лечение по соответствующему протоколу, в зависимости от его варианта (лимфобластный или миелобластный)


Хронический лимфолейкоз относится к опухолям, первично возникающим в костном мозге в результате опухолевой трансформации чаще В-лимфоцитов, реже Т-лимфоцитов и последующей их моноклональной пролиферацией. Хронический лимфолейкоз - это онкологическое заболевание лимфатической ткани, при котором опухолевые лимфоциты накапливаются в периферической крови, костном мозге и лимфатических узлах. В отличие от острых лейкозов, опухоль растет достаточно медленно, вследствие чего нарушения кроветворения развиваются лишь в поздних стадиях развития заболевания. Хронический лимфолейкоз представляет собой доброкачественную опухоль, ее субстрат составляют преимущественно морфологически зрелые лимфоциты. Болезнь проявляется лимфатическим лейкоцитозом, диффузной лимфоцитарной пролиферацией в костном мозге, увеличением лимфатических узлов, селезенки и печени. Хронический лимфолейкоз составляет 30% всех регистрируемых случаев лейкозов в Европе и Америке, значительно реже выявляется в Азии. Частота встречаемости заболевания 2, 7 -3, 0 на 100 тысяч населения. Болеют в основном лица старше 50 лет, мужчины в два раза чаще, чем женщины. В детском и юношеском возрасте заболевание встречается крайне редко. Заболеваемость хроническим лимфолейкозом наблюдается в 2 раза чаще у представителей белой расы, чем негроидной. При хроническом лимфолейкозе морфологическим субстратом опухоли являются зрелые В-лимфоциты, однако возможен и Т-лимфоцитарный лейкоз. Большинство случаев данного заболевания составляет В-клеточная форма (95%). На долю Т-клеточной формы приходится около 5% от всех наблюдений, в основном регистрируемых в странах Азии

Патогенез при хроническом лимфолейкозе При хроническом лимфолейкозе в опухолевый процесс вовлекаются разные клоны лимфоцитов. К настоящему времени кариологически подтверждена клональность Т- и В- форм хронического лимфолейкоза, также кариологические данные доказывают их мутационную природу. Опухолевая трансформация происходит на уровне ранних Влимфоцитов с последующим блоком в их дальнейшей дифференцировке и пролиферацией клона опухолевых клеток. Накопление опухолевых клеток связано с нарушением процессов регуляции апоптоза. Доказана сверхэкспрессия генов семейства Всl-2 в опухолевых Влимфоцитах, блокирующих апоптоз, что способствует удлинению продолжительности жизни этих клеток. Хронический лимфолейкоз - это медленно прогрессирующее заболевание. Опухоль постепенно вытесняет нормальные гемопоэтические клетки, что со временем приводит к развитию недостаточности костномозгового кроветворения. Пролиферация опухолевых Влимфоцитов в костном мозге, лимфатических узлах, селезенке, реже в других органах (кожа, желудочно-кишечный тракт, почки, легкие и др. ) обуславливает клиническую картину заболевания. Чаще всего первым симптомом хронического лимфолейкоза является увеличение размеров лимфатических узлов. Вследствие увеличения селезенки, возможно возникновение ощущения тяжести в животе. Нередко больные испытывают значительную общую слабость, теряют вес, у них повышена частота развития инфекционных заболеваний. Симптомы развиваются постепенно, в течение длительного времени. Примерно в 25% случаев заболевание обнаруживают случайно при анализе крови, назначенном по другому поводу (диспансеризация, обследование по поводу негематологического заболевания)

Клиническая картина при хроническом лимфолейкозе В классификации хронического лимфолейкоза имеются клинические формы, которые соответствуют классификации ВОЗ (2001 г. ). К ним относятся прогрессирующая, пролимфоцитарная и доброкачественная форма, как вариант течения) Уведичение шейных лимфатических узлов

Классификация при хроническом лимфолейкозе Доброкачественная форма. Об-но: лимфоузлы, селезенка могут быть нормальных размеров либо незначительно увеличены (чаще шейные узлы); консистенция эластическая. Величина узлов годами не меняется. В анализах крови - очень медленное, заметное лишь на протяжении 2 - 3 лет нарастание лейкоцитоза, редко превышающего 20 - 30. 109/л, абсолютного лимфоцитоза. Характерен очаговый тип роста опухоли в костном мозге. Так клетки составляющие «очаг» в костном мозге, более крупные и светлые, чем классические малые лимфоциты, нередко ставится диагноз «метастазы лимфосаркомы» . Отсутствие полиморфизма в гистологическом препарате и наличие «лимфоцитов лимфоцитомы» в цитологическом пунктате костного мозга позволяют установить правильный диагноз

Классификация при хроническом лимфолейкозе Прогрессирующая форма. Несмотря на сохраняющееся хорошее самочувствие, размеры лимфоузлов и лейкоцитоз нарастают по месяцам; последний может достигать 100 200. 109/л и выше. Первыми обычно увеличиваются шейные и надключичные лимфоузлы, затем - подмышечные. Консистенция лимфоузлов тестоватая. Селезенка вначале либо не пальпируется, либо незначительно увеличена, в дальнейшем ее размеры растут. Пролимфоцитарная форма. Об-но: селезенка обычно увеличена, лимфоаденопатия умеренная. В анализах крови невысокий лимфатический лейкоцитоз. В мазке крови преобладают пролимфоциты. Пролимфоцитарной форме В-клеточного хронического лимфолейкоза иногда сопутствует моноклональная секреция (обычно-Ig. M). Иммунофенотип соответствует хроническому лимфолейкозу, но CD 23 чаще отсутствует

Классификация при хроническом лимфолейкозе В соответствии с современной системой стадирования хронического лимфолейкоза, предложенной Международной рабочей группой по хроническому лимфолейкозу, выделяют три стадии: • Стадия А - лимфоцитоз при поражении не более 2 -х групп лимфатических узлов (или в отсутствие их поражения); тромбоцитопения и анемия отсутствуют. • Стадия В - поражены 3 и более группы лимфатических узлов; тромбоцитопения и анемия отсутствуют. • Стадия С - наличие тромбоцитопении или анемии независимо от числа пораженных групп лимфатических узлов. В зависимости от наличия тех или иных симптомов, к буквенному обозначению стадии хронического лимфолейкоза могут быть добавлены римские цифры: I - при наличии лимфаденопатии II - при увеличении селезенки (спленомегалии) III - при наличии анемии IV - при наличии тромбоцитопении Согласно рекомендациям экспертов ФАБ группы диагноз хронического лимфолейкоза считается установленным при абсолютном количестве лимфоцитов в крови, превышающем 10. 109/л, наличии более 30% лимфоцитов в костном мозге и иммунологическом подтверждении существования В-клеточного клона лейкемических клеток

Диагностика при хроническом лимфолейкозе В периферической крови в начальной стадии заболевания отмечается нормальный или незначительно повышенный уровень лейкоцитов, абсолютный лимфоцитоз. Как правило, анемия и тромбоцитопения отсутствуют. В лейкоцитарной формуле процент морфологически зрелых лимфоцитов составляет от 45 до 95%, встречаются единичные пролимфоциты. Имеет место относительная или абсолютная нейтропения. Лимфоциты периферической крови характеризуются небольшими размерами (7 - 10 мкм), округлым ядром, грубым, тяжистым распределением хроматина (крупноглыбчатый), отсутствием нуклеол, узкой, слабобазофильного цвета, цитоплазмой. Встречаются клетки цитолиза. Характерные признаки – (пятна) тени Боткина - Гумпрехта (полуразрушенные ядра лейкозных лимфоцитов)

Диагностика при хроническом лимфолейкозе В развернутой стадии заболевания нарастает лейкоцитоз, относительный и абсолютный лимфоцитоз, достигающий 600 -1000. 109/л, нейтропения. Наблюдается нормохромная анемия и/или тромбоцитопения. В лейкоцитарной формуле пролимфоциты составляют менее 10%, встречаются при просмотре препарата лимфобласты. Обнаружение лимфоцитов с расщепленными, перекрученными, неправильной формой ядрами, грубой тяжистой или волокнистой структурой хроматина свидетельствует о возможной лейкемизации лимфосаркомы или Т-клеточном варианте хронического лимфолейкоза. В периферической крови могут обнаруживаться единичные крови Общий анализ миелоциты и Общий анализ крови инфекционных заболеваний, а также метамиелоциты, обычно на фоне нормобласты Эритроциты – 2. 1. 10. 12/л, Нв - 82 г/л, ЦП - 0. 85, Лейкоциты - 152. 10. 9/л, п/я - 2%, с/я - 16%, лимф - 81%, м - 1%, СОЭ 64 мм/час Тромбоциты – 200. 10. 9/л Эритроциты – 2. 6. 10. 12/л, Нв - 87 г/л, ЦП - 0. 9, Лейкоциты - 142. 10. 9/л, п/я - 2%, с/я - 16%, лимф - 81%, м - 1%, СОЭ 54 мм/час Тромбоциты – 210. 9/л

Диагностика при хроническом лимфолейкозе • В миелограмме: в зависимости от стадии заболевания костный мозг может быть нормо- или гиперклеточным. По данным трепанобиопсии поражение костного мозга носит очаговый или диффузный характер. • Независимо от стадии заболевания диффузная инфильтрация костного мозга лимфоидными клетками сочетается с малой продолжительностью жизни больных (менее 43 месяцев) по сравнению с очаговой инфильтрацией (100 месяцев). • При исследовании костного мозга обнаруживается увеличение числа лимфоцитов до 40 - 60%. Со временем без лечения число лимфоцитов возрастает до 70 - 99%, вплоть до тотальной мономорфной лимфоидной инфильтрации. • Уменьшение числа эритрокариоцитов при этом не всегда сопровождается развитием анемии, поскольку общий плацдарм эритроидного кроветворения оказывается еще достаточным. Возможно относительное уменьшение числа гранулоцитов в крови и в костном мозге, но абсолютное их число может быть нормальным или уменьшенным. На сегодняшний день в диагностике лейкозов применяется иммунофенотипирование, которое представляет собой одно из наиболее востребованных клинических приложений проточной цитометрии. Иммунодиагностика гемобластозов основана на сопоставлении морфофункциональных характеристик лейкозных и нормальных (нетрансформированных) клеток гемопоэза. Цитограмма лимфатических узлов характеризуется пролиферацией мономорфной популяции морфологически зрелых лимфоцитов

Лечение при хроническом лимфолейкозе В отличие от многих других опухолей, большинство ученых считают, что при хроническом лимфолейкозе не целесообразно проведение терапии в ранних стадиях заболевания. Это обусловлено тем, что у большинства пациентов в начальных стадиях хронического лимфолейкоза заболевание носит «тлеющий» характер, и больные могут долгое время обходиться без лечения, нормально себя чувствуя и сохраняя привычный образ жизни. Лечение необходимо начинать лишь при появлении признаков прогрессирования заболевания, к которым относят: - Быстрое нарастание числа лимфоцитов в крови (свыше 150. 109/л), удвоение абсолютного числа лимфоцитов в крови менее чем за 12 месяцев, - Прогрессирующее увеличение лимфатических узлов, - Значительное увеличение селезенки - Нарастание анемии и тромбоцитопении - Увеличение подверженности бактериальным инфекциям, - Массивная лимфоцитарная инфильтрация костного мозга (более 80%), лимфоцитов в миелограмме), - Наличие комплексных хромосомных аббераций, - Продвинутая стадия болезни (С по J. Binet еt al. , III-IV по Rai). - Появление симптомов опухолевой интоксикации - лихорадки, ночных потов, потери веса, выраженной слабости

Лечение при хроническом лимфолейкозе Химиотерапия: - Ранее «золотым стандартом» считался хлорбутин, - В настоящее время «золотой стандарт» : СОР=циклофосфан+винкристин+преднизолон, СНОР=циклофосфан+винкристин+адриабластин+преднизолон, М-2=кармустин+циклофосфан+ винкристин+меофелан (алкеран)+ преднизолон, Иммунохимиотерапия, особенно режим FCR: - флюдарабин, - циклофосфамид, - ритуксимаб, - Алемтузумаб. - Биоиммунотерапия с применением моноклональных антител, селективно уничтожают опухолевые клетки, не повреждая здоровые. - Высокозодная химиотерапия с трансплантацией кроветворных стволовых клеток, - Лучевая терапия в качестве вспомогательного метода при наличии большой опухолевой массы, - Спленэктомия при значительном увеличении органа

Эритремия Эритремия - хронический лейкоз с перерождением на уровне клеткипредшественницы миелопоэза с характерной для опухоли неограниченной пролиферацией этой клетки, сохраняющей способность дифференцироваться по 4 росткам, преимущественно по красному. На определенных этапах заболевания, а иногда и с самого начала, к пролиферации клеток в костном мозге присоединяется миелоидная метаплазия в селезенке. В клинической картине эритремии наблюдается три стадии: В I стадии, продолжительность которой составляет 5 лет и более, наблюдаются умеренная плетора, селезенка не пальпируется. В крови на этой стадии преобладает умеренный эритроцитоз. В костном мозге картина панмиелоза. Во IIa стадии (эритремической) выражены плетора, спленомегалия, гепатомегалия, тромбозы, геморрагические осложнения. В периферической крови наблюдается эритремия, тромбоцитоз, нейтрофилез со сдвигом формулы влево. В костном мозге - тотальная трехростковая гиперплазия с выраженным мегакариоцитом. Во IIb стадии к вышеперечисленным признакам присоединяется миеломная метаплазия селезенки. III стадия - анемическая. В костном мозге выражен миелофиброз, миелопоэз может быть сохранен или угнетен, возможен переход в острый лейкоз или хронический миелолейкоз

Эритремия (плеторический синдром)

Диагностика эритремии В периферической крови: количество эритроцитов увеличено и обычно составляет 6. 10¹²/л-8. 10¹²/л в 1 л и более. Гемоглобин повышается до 180 -220 г/л, цветовой показатель меньше единицы (0, 7 -0, 6). Общий объем циркулирующей крови значительно увеличен в 1, 5 -2, 5 раза, в основном за счет увеличения количества эритроцитов. Показатели гематокрита (соотношение эритроцитов и плазмы) резко меняются за счет повышения эритроцитов и достигает значения 65% и более. Заподозрить эритремию можно у мужчин при наличии Эр. > 5, 7. 1012/л, Нв>177 г/л, Ht 52%, у женщин Эр. >5, 2. 1012/л, Нв>172 г/л, Ht 48 -40% Общий анализ крови Эритроциты – 6. 4. 10. 12/л, Нв – 179 г/л, ЦП - 0. 8, Лейкоциты -16. 10. 9/л, п/я - 2%, с/я - 67%, лимф - 30%, м - 1%, СОЭ 1 мм/час Тромбоциты – 600. 10. 9/л Эритроциты – 6. 4. 10. 12/л, Нв - 184 г/л, ЦП - 0. 8, Лейкоциты -26. 10. 9/л, п/я - 2%, с/я - 67%, лимф - 30%, м - 1%, 2 мм/час Тромбоциты – 600. 10. 9/л

Диагностика эритремии Число ретикулоцитов в крови повышено до 15 -20 промилле, что свидетельствует об усиленной регенерации эритроцитов. Отмечается полихромазия эритроцитов, в мазке можно обнаружить отдельные эритробласты. Отсутствие вторичных эритроцитозов Наличие генетических аномалий в клетках костного мозга, кроме наличия хромосомной транслокации Филадельфийской хромосомы или с перестроенным геном BCR ABL. Увеличено количество лейкоцитов в 1, 5 - 2 раза до 10, 0. 109/л-12, 0. 109/л в литре крови (при отсутствии температурной реакции, инфекций и интоксикаций). У некоторых больных лейкоцитоз достигает более высоких цифр. Увеличение происходит за счет нейтрофилов, содержание которых достигает 70 - 85%. Наблюдается палочкоядерный, реже миелоцитарный сдвиг. Увеличивается количество эозинофилов, реже и базофилов. Число тромбоцитов увеличено до 400, 0. 109/л-600, 0. 109/л в литре крови, а иногда и больше. Вязкость крови значительно повышена. СОЭ замедлена (1 -2 мм за час)

Диагностика эритремии Диагностические критерии истинной полицитемии. Группа по изучению истинной полицитемии, США) Категория А: • Увеличение массы циркулирующих эритроцитов • Нормальное насыщение артериальной крови кислородом (> 92%) • Увеличение селезенки. Категория Б: • Количество лейкоцитов в периферической крови>12. 109/л (при отсутствии температурной реакции, инфекций, интоксикаций) • Количество тромбоцитов в периферической крови>400. 109/л • Активность щелочной фосфотазы нейтрофилов>100 ед. (при отсутствии температурной реакции, инфекций, интоксикаций) • Содержание витамина В 12 в крови>900 пг/мл, В 12 -связывающая способность сыворотки крови>2200 пг/мл

Лечение эритремии В основе лечения эритремии лежат уменьшение вязкости крови и борьба с осложнениями - тромбообразованием и кровотечениями. Вязкость крови, напрямую связана с количеством эритроцитов, поэтому кровопускание и химиотерапия (циторедуктивная терапия), уменьшающие массу эритроцитов, нашли применение при лечении истинной полицитемии. Кровопускание остаётся ведущим методом лечения эритремии. Кровопускания, • Цитостатики–миелосан 4 -6 мг в сутки, гидроксимочевина (гидреа) 20 - 40 мг на кг массы тела, миелобромол, лейкеран, пипоброман, анагрелид, • Антиагреганты (аспирин в дозе 1 г. в сутки), антикоагулянты (гепарин 20000 ед. в сутки), • Антигистаминные препараты применяются местно при кожном зуде, • Свежезамороженная плазма применяется при развитии геморрагического синдрома, • При выраженном гиперспленизме применяют спленэктомию, • Реже применяют лечение радиоактивным фосфором (32 Р). Дополнительно применяют средства симптоматического действия: - эритроцитоферез, - циторедуктивная терапия (антиметаболиты, алкилирующие, биологические вещества), - андрогенные препараты (винобанин), эритропоэтин при дефиците железа, - аллопуринол для снижения уровня мочевой кислоты, - преднизолон, - спленэктомия при выраженном гиперспленизме

Осложнения и исход эритремии Осложнения болезни возникают из-за тромбозов и эмболий артериальных и венозных сосудов головного мозга, селезенки, печени, нижних конечностей, реже в других областей тела. Развиваются инфаркт селезенки, ишемический инсульт, инфаркт сердца, цирроз печени, тромбоз глубоких вен бедра. Наряду с тромбозами отмечаются кровотечения, эрозии и язвы желудка и двенадцатиперстной кишки, анемии. Очень часто развиваются желчнокаменная и мочекаменная болезнь из-за повышения концентрации мочевой кислоты, нефросклероз. Течение полицитемии хроническое доброкачественное. При современных методах лечения больные живут долго. Длительность жизни с болезнью более 10 лет. Исходом болезни может быть развитие миелофиброза с прогрессирующей анемией гипопластического типа и трансформация болезни в миелолейкоз

Геморрагические диатезы (2 уровень) В этом разделе мы изучаем три заболевания: 1. Аутоиммунная тромбоцитопеническая пурпура 2. Гемофилия 3. Геморрагический васкулит. В обеспечении нормального гемостаза участвуют тромбоциты (тромбоцитарный компонент), факторы свертывания крови (плазменный компонент) и сосудистая стенка (сосудистый компонент). Фибринолитическая система обеспечивает растворение избыточных тромботических масс

Типы кровоточивости

Болезнь Верльгофа (хроническая иммунопатологическая тромбоцитопеническая пурпура) — хроническое волнообразно протекающее заболевание, представляющее собой первичный геморрагический диатез, обусловленный количественной и качественной недостаточностью тромбоцитарного звена гемостаза. Характеризуется элиминативной тромбоцитопенией, наличием гигантских тромбоцитов в кровотоке, мегакариоцитозом в костном мозге и обязательным присутствием антитромбоцитарных аутоантител, то есть нарушением мегакариоцитарно-тромбоцитарной системы. Болезнь названа по имени немецкого врача П. Верльгофа, описавшего её в 1735 году. Тромбоцитопеническая пурпура (болезнь Верльгофа) - заболевание, характеризующееся склонностью к кровоточивости, обусловленной тромбоцитопенией (снижением содержания тромбоцитов в крови до 150× 109/л) при нормальном или увеличенном количестве мегакариоцитов в красном костном мозге

хроническая иммунопатологическая тромбоцитопеническая пурпура Как показали наблюдения, тромбоцитопения при болезни Верльгофа зависит от функционального поражения мегакариоцитов, выражающегося в нарушенном процессе «отшнурования» кровяных пластинок. В настоящее время патогенез большинства функциональных тромбоцитопений (не связанных с органической аплазией костного мозга) рассматривают в свете иммуногематологии как заболевание аутоиммунной, реже изоиммунной природы. Иммуноаллергический характер тромбоцитопении устанавливают на основании соответствующих лабораторных тестов (обнаружение антитромбоцитарных антител, положительные пробы Кумбса). В пользу иммунологического характера заболевания говорит и благоприятный эффект лечения кортикостероидными гормонами

хроническая иммунопатологическая тромбоцитопеническая пурпура Характерные изменения внутренних органов при тромбоцитопенической пурпуре отсутствуют. Температура тела обычно нормальная. Иногда выявляют тахикардию, при аускультации сердца - систолический шум на верхушке и в точке Боткина, ослабление I тона, обусловленные анемией. Увеличение селезёнки нехарактерно и скорее исключает диагноз тромбоцитопенической пурпуры. Увеличение печени и селезенки — непостоянные симптомы; со стороны других внутренних органов изменений почти не наблюдается. В зависимости от клинических проявлений и результатов лабораторных исследований различают легкие, средней тяжести и тяжелые формы тромбоцитопенической пурпуры, а по течению — острые и хронические. По течению выделяют острые (длительностью до 6 месяцев) и хронические (продолжительностью более 6 месяцев) формы заболевания. При первичном осмотре установить характер течения заболевания невозможно. В зависимости от степени проявления геморрагического синдрома, показателей крови в течении заболевания выделяют три периода: геморрагический криз, клиническая ремиссия и клиникогематологическая ремиссия

хроническая иммунопатологическая тромбоцитопеническая пурпура Нарушается тромбоцитарно - сосудистый гемостаз. Характерны синяки и геморрагии различной величины и формы на коже; кровотечения из носа, десен. Основными клиническими симптомами тромбоцитопенической пурпуры являются кровоизлияния в кожные покровы и кровотечения из слизистых оболочек, которые развиваются как бы спонтанно, под влиянием мельчайших, едва заметных травм. Кровоизлияния в кожу различны как по величине (от булавочной головки до блюдца), так и по цвету: в зависимости от давности кровоизлияние меняет свою первоначальную пурпурную окраску, приобретая последовательно лиловый, синий, зеленоватый, бурый или желтый оттенок, одновременно становясь все бледнее. Симптомы «щипка» и «жгута» . Излюбленными местами расположения экхимозов и петехий на коже является передняя поверхность туловища и конечностей; реже кровоизлияния наблюдаются на лице. Кровотечения возникают спонтанно; появлению синяков способствуют ушибы. Характерны синяки и геморрагии различной величины и формы на коже; кровотечения из носа, десен

Кожные проявления при болезни Верльгофа

хроническая иммунопатологическая тромбоцитопеническая пурпура

хроническая иммунопатологическая тромбоцитопеническая пурпура Нередки при тромбоцитопенической пурпуре кровотечения из внутренних органов (желудочно-кишечные, легочные, почечные) и кровоизлияния в плевру, брюшную полость, мозг, склеру и сетчатку глаза, кровотечения из матки, иногда из почек, желудочнокишечного тракта. Кровотечения возникают спонтанно; появлению синяков способствуют ушибы. Спленомегалия отсутствует. Заболевание осложняется хронической железодефицитной анемией различной тяжести. Кровоизлияние в склеру может указывать на угрозу возникновения самого тяжёлого и опасного осложнения тромбоцитопенической пурпуры - кровоизлияния в головной мозг. Как правило, оно возникает внезапно и быстро прогрессирует. Исход кровоизлияния в мозг зависит от объёма, локализации патологического процесса, своевременности диагностики и адекватной терапии. У девушек могут быть маточные кровотечения. У девочек тромбоцитопеническая пурпура нередко обнаруживается с появлением первых месячных, принимающих характер профузного кровотечения. У женщин в клинической картине болезни нередко доминируют маточные кровотечения (мено- и метроррагии). Кровоизлияние в брюшину в связи с овуляцией может имитировать картину внематочной беременности. Наклонность к кровотечениям из гениталий у женщин, больных тромбоцитопенической пурпурой, объясняется снижением количества тромбоцитов во время менструаций. Если у здоровых женщин на 1 - 2 -й день менструации количество пластинок в крови снижается на 30 - 50%, то у больных тромбоцитопенической пурпурой в дни менструаций пластинки почти исчезают, сгусток становится ирретрактильным и время кровотечения резко удлиняется. Одновременно или за несколько дней до наступления менструаций обнаруживаются общие геморрагические явления (синяки на теле, носовые и другие кровотечения)

хроническая иммунопатологическая тромбоцитопеническая пурпура Геморрагический криз характеризуется выраженным синдромом кровоточивости, значительными изменениями лабораторных показателей. Во время клинической ремиссии исчезает геморрагический синдром, сокращается время кровотечения, уменьшаются вторичные изменения в свёртывающей системе крови, но тромбоцитопения сохраняется, хотя она менее выраженная, чем при геморрагическом кризе. Клинико-гематологическая ремиссия подразумевает не только отсутствие кровоточивости, но и нормализацию лабораторных показателей. Клинически диагноз аутоиммунной тромбоцитопении предполагают на основании отсутствия семейного анамнеза и других признаков наследственного дефицита тромбоцитов, а также положительного результата стероидной терапии. Основным гсматологическим признаком являются количественные и качественные изменения тромбоцитов. Тромбоцитопения - наиболее постоянный симптом. В периоды кровотечений количество кровяных пластинок в препарате резко уменьшено и колеблется от 0 до 7. 109/л. В периоды ремиссии количество пластинок увеличивается, но, как правило, не достигает нормы. Качественные изменения сводятся к появлению гигантских тромбоцитов причудливой формы (в виде цепочек). Помимо изменения тромбоцитов, значительно увеличено время кровотечения (при норме 2— 3 мин, может быть 15— 30 мин и более) и снижена или отсутствует ретракция кровяного сгустка. На высоте тромбоцитопенических кровотечений сгусток полностью утрачивает способность к ретракции и остается рыхлым, сыворотка не отделяется. В периоды ремиссии ретракция сгустка становится нормальной. крови становится нормальной

хроническая иммунопатологическая тромбоцитопеническая пурпура Время кровотечения в период обострения тромбоцитопенической пурпуры резко удлинено (до 30 мин. и более). Длительность кровотечения не всегда соответствует степени тромбоцитопении, так как она зависит не только от количества тромбоцитов, но и от их качественных характеристик Свертываемость крови может быть замедлена за счет дефицита третьего тромбопластического фактора пластинок; в период ремиссии, а также после спленэктомии свертываемость. У всех больных с тромбоцитопенией снижена концентрация серотонина в крови. Эндотелиальные пробы (жгута, щипка, молоточковая, уколочная) в период гематологического криза положительны. В красной крови и лейкограмме (при отсутствии кровопотерь) изменений не находят. При исследовании красного костного мозга обычно выявляют нормальное или повышенное содержание мегакариоцитов. Имеются гигантские клетки, которые морфологически нормальные, но функционально недеятельные (не происходит образования кровяных пластинок)

хроническая иммунопатологическая тромбоцитопеническая пурпура В стадии ремиссии, а также в случаях, проявляющихся лишь подкожными (или подслизистыми) кровоизлияниями без наружных или внутренних кровотечений, картина крови нормальна. В связи с кровопотерями развивается постгеморрагическая анемия. При длительных и повторных кровотечениях анемия приобретает гипорегенераторный и даже гипопластический характер. Со стороны белой крови при обычном течении болезни не наблюдается изменений; при кровопотере — нейтрофильный лейкоцитоз до 10. 109/л; с развитием гипорегенераторного (гипопластического) состояния кроветворения отмечается лейкопения (за счет гранулоцитопении). Во время ремиссий количество кровяных пластинок в крови увеличивается, достигая в некоторых случаях нижней границы нормы (10. 109/л) или полной нормы

Лечение хронической иммунопатологической тромбоцитопенической пурпуры Глюкокортикостероиды. Иммуноглобулины для внутривенного введения Цитостатическиме препаратаы Инфузия тромбоцитов Плазмаферез

Гемофилия Свертываемость крови (гемостаз) является важной защитной реакцией организма, активизирующейся при повреждении сосудов и кровотечении. Ее обеспечивают особые вещества, называемые факторами свертывания крови, а также мелкие кровяные тельца, или тромбоциты. Успешное завершение процесса свертывания крови и остановки кровотечения возможно только при наличии всех факторов свертывания, а также достаточном количестве тромбоцитов. При дефиците тех или иных факторов свертывания крови своевременный гемостаз становится невозможным, то есть, возникает гемофилия. Эту группу составляют геморрагические диатезы, обусловленные нарушениями в свертывающей системе крови. Среди наследственных форм подавляющее большинство случаев (более 95%) приходится на дефицит компонентов фактора VIII (гемофилия А, болезнь Виллебранда) и фактора IX (гемофилия В), по 0, 3 - 1, 5% приходится на дефицит факторов VII, X, V и XI. Крайне редки (единичные наблюдения) формы, связанные с наследственным дефицитом других факторов, а именно XII (дефект Хагемана), II (гипопротромбинемия), I (гиподисфибриногенемия), XIII (дефицит фибринстабилизирующего фактора). В зависимости от того, дефицит какого фактора свёртывающей системы крови имеет место, выделяют два основных вида гемофилии: • гемофилия А, которая характеризуется низким содержанием антигемофильного глобулина (белка) - фактора VIII; • гемофилия В. Она сопровождается нарушением свёртывания вследствие недостаточности тромбопластина (фактора IX) в плазме крови

Гемофилия — классическая форма наследственной кровоточивости; болеют ею, как правило, мужчины. Заболевание от отца – «гемофилика» может передаваться внуку только через внешне здоровую дочь, которая может служить передатчицей, или так называемым кондуктором, болезни. Наследование гемофилии происходит по рецессивному признаку, сцепленному с патологической половой хромосомой. Гемофилия В встречается в 5 раз реже, чем гемофилия А. Гемофилией А и В болеют главным образом мужчины. Это объясняется тем, что патологическая хромосома X, на которой расположен ген заболевания, передаётся из поколения в поколение от больного мужчины к дочерям. Однако при этом девочки сами гемофилией не страдают, ввиду того, что аномальная отцовская Х хромосома компенсируется у них полноценной материнской. Именно поэтому женщины являются носительницами гемофилии, передавая измененную Х хромосому сыновьям, которые унаследуют отцовский недуг. Мальчики, которые рождаются у такой женщины, имеют 50 % шанс получить это заболевание. У самих носителей, как правило, признаков гемофилии нет. Однако мальчики могут остаться и здоровыми без патологических генов, если получат материнскую генетическую информацию. Девочки болеют гемофилией лишь в том случае, если унаследуют от обоих родителей измененные Х хромосомы

Гемофилия Схема генетической передачи гемофилии

Гемофилия Из истории известно, что в царских семьях существовало немало случаев развития гемофилии. Самой известной носительницей гемофилии была королева Виктория; по-видимому, эта мутация произошла в её генотипе denovo, поскольку в семьях её родителей страдающие гемофилией не зарегистрированы. Теоретически, это могло бы произойти и в том случае, если бы отцом Виктории являлся в действительности не Эдуард Август, герцог Кентский, а какой-либо другой мужчина (больной гемофилией), однако никаких исторических свидетельств в пользу этого не существует. Гемофилией страдал один из сыновей Виктории (Леопольд, герцог Олбани), а также ряд внуков и правнуков (родившихся от дочерей или внучек), включая российского царевича Алексея Николаевича. По этой причине данное заболевание получило такие названия: «викторианская болезнь» и «царская болезнь» . Также иногда в царских фамилиях для сохранения титула допускались браки между близкими родственниками, отчего частота встречаемости гемофилии была выше

Гемофилия

Гемофилия может проявить себя в любом возрасте. Чаще всего болезнь протекает бессимптомно и случайно выявляется при исследовании свертывающей системы крови. Спонтанная кровоточивость отсутствует или незначительна. Травмы и операции в ряде случаев (не всегда даже у одного и того же больного) осложняются кровотечениями. У детей гемофилия может проявиться с первых дней жизни: пуповинное кровотечение у новорождённых, родовая кефалогематома и подкожные кровоизлияния. На протяжении первого года жизни у младенцев, страдающих гемофилией, обильные кровотечения возникают при влении зубов. Заболевание чаще диагностируют в старшем возрасте, когда ребенок становится более активным, начинает ходить, ползать, играть, в результате чего в значительной степени возрастает риск травматизации

Гемофилия Для гемофилии свойственна кровоточивость гематомного типа, которая характеризуется формированием гемартрозов (кровь в суставах), гематом (кровоизлияния в мягкие ткани) и отсроченных (поздних) кровотечений. Типичным симптомом болезни являются суставные кровоизлияния (гемартрозы). Они, как правило, очень болезненны, часто сопровождаются лихорадкой и симптомами интоксикации. Чаще всего страдают крупные суставы – коленные, локтевые, голеностопные, несколько реже – тазобедренные, плечевые и кисть. После первичного кровоизлияния, кровь постепенно рассасывается, что приводит к полному восстановлению функции конечности

Гемофилия При многократных повторных повреждениях образуются фибриновые сгустки, которые откладываются на внутренней поверхности капсулы и хрящах, после чего прорастают соединительной тканью (рис. 11). В результате таких органических изменений тканей сустава, синовиальная полость облитерируется (суживается) и, как следствие патологического процесса, развивается анкилоз (сращение обеих костей, формирующих сустав) с последующим развитием хронических артрозов с деформацией и ограничением подвижности суставов, атрофией мышц и контрактурами, инвалидизирующих больных, заставляющих их пользоваться ортопедической коррекцией, костылями, инвалидными колясками. Возможны большие межмышечные, внутримышечные, поднадкостничные и забрюшинные гематомы, вызывающие иногда деструкцию подлежащей костной ткани (гемофилические псевдоопухоли), патологические переломы костей. Возможны упорные рецидивирующие желудочно-кишечные и почечные кровотечения

Гемофилия

гемофилия

Гемофилия Регулярно возникают межмышечные гематомы, имеющие тенденцию к медленному рассасыванию. Излившаяся кровь длительное время сохраняет жидкие свойства, поэтому хорошо проникает в мягкие ткани и фасции. В некоторых случаях гематомы могут быть настолько обильными, что сдавливают магистральные нервные стволы, крупные артерии и вены, вызывая при этом соответственно параличи либо гангрены. Такие состояния, сопровождающиеся некрозом (омертвением) тканей, проявляются выраженным болевым синдромом

Лабораторные признаки гемофилии Удлинение общего времени свертывания крови при нормальных показателях протромбинового и тромбинового тестов. Для дифференциальной диагностики гемофилии А и В используют тест генерации тромбопластина, коррекционные пробы в аутокоагулограмме: при гемофилии А нарушение свертываемости устраняется добавлением в плазме больного донорской плазмы, предварительно адсорбированной сульфатом бария (при этом удаляется фактор IX, но сохраняется фактор VIII), но не устраняется нормальной сывороткой, продолжительность хранения которой 1 -2 суток (содержит фактор IX, но лишена фактора VIII); при гемофилии В коррекцию дает старая сыворотка, но не Ва. SO 4 плазма. При наличии в крови больного иммунного ингибитора антигемофилического фактора ("ингибиторная" форма гемофилии) коррекцию не дают ни Ва. SO 4 -плазма, ни старая сыворотка, мало нарастает уровень дефицитного фактора в плазме больного после в/в введения его концентрата или донорской плазмы. Титр ингибитора определяют по способности разных разведении плазмы больного нарушать свертываемость свежей нормальной донорской плазмы

Гемофилия Основные показатели коагулограммы и их изменения для больных гемофилией: • Увеличение времени свёртывания цельной крови; • Увеличение АЧТВ (активированного частичного тромбопластинового времени); • Определение степени снижения свертывающей активности антигемофильных факторов плазмы (VIII, IX)

Лечение гемофилии Заместительная гемостатическая терапия криопреципитатом или концентратами фактора VIII (при гемофилии А) или фактор IX - препарат ППСБ (при гемофилии В). Показаниями к заместительной терапии являются кровотечения, острые гемартрозы и гематомы, острые болевые синдромы неясного генеза (часто связаны с кровоизлияниями в органы), прикрытие хирургических вмешательств (от удаления зубов до полостных операций). Лечение гемофилии основано на внутривенном введении дефицитного фактора свертывания крови. Терапия может либо предотвратить кровотечение, либо уменьшить его последствия

Геморрагический васкулит ГЕМОРРАГИЧЕСКИЙ ВАСКУЛИТ (болезнь Шенлейна - Геноха) - системное поражение капилляров, артериол, венул, главным образом кожи, суставов, брюшной полости и почек. Геморрагический васкулит (анафилактоидная пурпура, иммунный микротромбоваскулит, болезнь Шенлейна - Геноха) - кровоточивость, обусловленная поражением сосудов малого калибра иммунными комплексами и компонентами системы комплемента. Геморрагический васкулит - острое инфекционно-аллергическое заболевание, при котором поражаются мелкие сосуды кожи, суставов, кишечника и почек. Геморрагический васкулит- иммунопатологическое заболевание, характеризующееся системным васкулитом — воспалением сосудов. Чаще болеют мальчики

Классификация геморрагического васкулита По формам: кожная и кожно-суставная: - простая - некротическая - с холодовой крапивницей и отеками абдоминальная и кожно-абдоминальная почечная и кожно - почечная (в том числе с нефротическим синдромом) смешанная По течению: молниеносное течение (часто развивается у детей до 5 лет) острое течение (разрешается в течение 1 месяца) подострое (разрешается до трех месяцев) затяжное (разрешается до шести месяцев) хроническое

Геморрагический васкулит По степени активности I степень активности — состояние при этом удовлетворительное, температура тела нормальная или субфебрильная, кожные высыпания необильные, все остальные проявления отсутствуют, СОЭ увеличено до 20 миллиметров в час. II степень активности — состояние средней тяжести, выраженный кожный синдром, повышается температура тела выше 38 градусов(лихорадка), выраженный интоксикационный синдром (головная боль, слабость, миалгии), выраженный суставной синдром, умеренно выраженный абдоминальный и мочевой синдром. В крови повышено количество лейкоцитов, нейтрофилов, эозинофилов, СОЭ будет повышено до 20— 40 миллиметров в час, снижается содержание альбуминов, диспротеинемия. III степень активности — состояние будет уже тяжелым, выражены симптомы интоксикации (высокая температура, головная боль, слабость, миалгии).

Геморрагический васкулит Выражен кожный синдром, суставной, абдоминальный (приступообразные боли в животе, рвота, с примесью крови), выраженный почечный синдром, может быть поражение центральной нервной системы и периферической нервной системы. В крови выраженное повышение лейкоцитов, повышение нейтрофилов, повышение СОЭ выше 40 миллиметров в час, может быть анемия, снижение тромбоцитов. По клинической картине выделяют легкие, средней тяжести и тяжелые формы, по течению — острые, подострые, хронические. - острое течение заболевания. При остром течении заболевание начинается внезапно и течет бурно с многосимптомной клиникой болезни, часто осложняясь нефритом. - хроническое течение. При хроническом течении большей частью речь идет о рецидивирующем кожно-суставном синдроме (ортостатическая пурпура пожилых) •

Геморрагический васкулит Симптомы геморрагического васкулита • кожный • суставной • абдоминальный • почечный • злокачественный с молниеносным течением Все перечисленные синдромы геморрагического васкулита в разной степени выраженности могут комбинироваться друг с другом. При геморрагическом васкулите в процесс могут быть вовлечены сосуды любой области, в том числе легких, мозга и его оболочек

Геморрагический васкулит, кожный синдром

Геморрагический васкулит Суставной синдром у больного геморрагическим васкулитом Абдоминальный синдром у больного геморрагическим васкулитом

Геморрагический васкулит Диагноз геморрагического васкулита выставляют на основании клинических данных. Лабораторные данные малохарактерны. В анализе периферической крови обнаруживают разной степени выраженности лейкоцитоз, наиболее выраженный при абдоминальном синдроме, со сдвигом формулы влево вплоть до юных, ускорение СОЭ, особенно при абдоминальном синдроме и полиартритах, нейтрофилез, эозинофилию, тромбоцитоз в начале заболевания, повышение содержания глобулинов в сыворотке, гиперфибриногенемия. В моче обнаруживают эритроциты и белок. Диагноз выставляется на основе обнаружения в крови иммунных комплексов и биопсия пораженных участков и сосудистой стенки

Геморрагический васкулит

Лечение геморрагического васкулита Высокая активность процесса с выраженным абдоминальным, кожным и суставным синдромом является показанием к назначению сочетания следующих препаратов: преднизолон и гепарин. Изолированное назначение преднизолона опасно, так как он способствует повышению свертываемости крови, а склонность к развитию ДВС‑синдрома при этом заболевании имеется всегда (даже если нет четких признаков его наличия). Преднизолон обычно назначают в дозе 1 мг/кг, а гепарин 200– 300 ЕД/кг в сутки, разделенных на 4– 6 введений, под кожу живота. Если на фоне гепаринотерапии время свертывания венозной крови продолжает оставаться укороченным (менее 8 мин), то дозу можно увеличить в 1, 5 раза, вводить до ликвидации признаков гиперкоагуляции

Геморрагический васкулит Всем больным с геморрагическим васкулитом необходимо назначение энтеросорбентов, например активированного угля, холестирамина или полифепана внутрь, противоаллергические препараты (антигистаминные), пантотенат кальция, рутин, средние дозы аскорбиновой кислоты, применяется и фитотерапия. Оправданным считается применение дезагрегантов, таких как курантил, пентоксифиллин (трентал). Продолжительность лечения составляет 3 месяца. При среднетяжелом течении геморрагического васкулита рекомендуют применять 2 дезагреганта, а при хроническом течении рассматриваемой патологии необходимо добавлять к терапии плаквинил (делагил). Длительность такой терапии может продолжаться до 1 года. Также рекомендуется назначение препаратов с мембраностабилизирующим действием (витамины А, Е, димефосфон)

Геморрагический васкулит Осложнения: инвагинация, перфорация, перитонит, желудочно-кишечное кровотечение, острая постгеморрагическая анемия

Гематология СПАСИБО ЗА ВНИМАНИЕ
лекцйииГематология(15-16).ppt